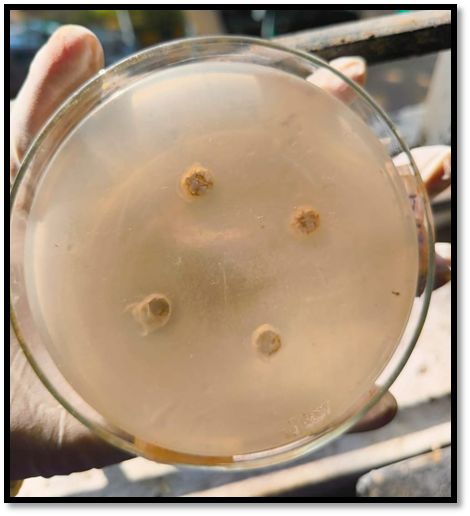

We use cookies to ensure our website works properly and to personalise your experience. Cookies policy

We use cookies to ensure our website works properly and to personalise your experience. Cookies policy
Maharashtra Institute of Pharmacy (B. Pharm), Betala, Bramhapuri, Maharashtra
This study aimed to develop and evaluate herbal ointments containing extracts of Maytenus emarginata and Curcuma longa, prepared by maceration with ethanol. The ointments were formulated using the fusion method with coconut oil, beeswax, and paraffin as bases. Three formulations, F1, F2, and F3, were prepared with varying concentrations of the bases. The ointments were evaluated for their in vitro performance in a E. Coli culture media, and all three formulations showed satisfactory results, indicating their potential for topical application. The study highlights the possibility of developing effective herbal ointments using Maytenus emarginata and Curcuma longa extracts, which can be explored further for their therapeutic benefits.
The research aimed to evaluate the phytochemical composition of Maytenus emarginata leaves and stems, focusing on identifying bioactive compounds such as phenols and flavonoids. These compounds are known for their antioxidant and anti-inflammatory properties, which can be beneficial for wound healing. Antioxidants help neutralize free radicals, reducing oxidative stress that can impede the healing process. Anti-inflammatory agents can reduce inflammation, a common issue in burn injuries. Burn wounds are susceptible to infections by various bacterial pathogens, which can complicate the healing process. The study assessed the antibacterial activity of Maytenus emarginata extracts against several bacterial strains. The results indicated that the leaf extract better antibacterial activity, suggesting a potential role in preventing or treating infections in burn wounds. The study looks on the antibacterial qualities and phytochemical makeup of the leaves and stem of Maytenus emarginata. There are still a number of research gaps, though. First off, although the study finds phytochemicals, it doesn't separate or describe the precise bioactive substances that have antibacterial properties. Furthermore, the mode of action against bacterial strains is still unknown. Furthermore, toxicity and safety assessments—which are essential for therapeutic applications—are absent from the study. Additionally, it only concentrates on in vitro antibacterial activity, hence in vivo research is required to verify effectiveness in biological systems Furthermore, a comparative analysis with standard antibiotics is missing, which could help determine its potential as an alternative antimicrobial agent. Lastly, the study does not explore drug formulation possibilities, limiting its practical application. Addressing these gaps through advanced biochemical, pharmacological, and clinical studies would enhance the medicinal value of Maytenus emarginata for antibacterial treatments. This study help to develop the various topical formulations based on Maytenus emarginata based gels, ointments or creams for topical application on burn. Further research is needed to validate the effectiveness and safety of Maytenus extracts on burn wounds through in vivo and clinical trials.
Skin Burn
The skin, being the largest organ in the body, plays essential roles such as maintaining the body’s shape, absorbing substances, safeguarding internal organs, retaining fluids, regulating temperature, assisting with sensory functions, and defending against diseases. Burns are one of the most frequent types of skin injuries across all age groups, making skin conditions a significant global health issue. A burn occurs when thermal, electrical, chemical, or ionizing radiation causes partial or complete damage to the skin or its underlying tissues [1]. Figure 1a illustrates the structure of human skin. The thickness of the skin’s layers can vary depending on the body region. On the forearm, the outermost layer, known as the stratum corneum, is roughly 0.05 mm thick, while the epidermis measures about 0.1 mm. Beneath the epidermis lies the dermis, which is approximately 0.5 to 0.7 mm thick. The thickness of the subcutaneous fat layer can differ significantly within the same person, depending on their nutritional condition. The skin also contains sweat ducts and hair shafts, which sometimes extend into the subcutaneous fat. These structures are lined with epidermal cells. Epithelial cells from surrounding healthy tissues, including those found in sweat ducts and hair shafts, migrate to the wounded area to aid in healing. The skin’s blood supply has two main layers: one located just below the epidermis and another deeper plexus near the boundary between the dermis and subcutaneous fat. Both layers play a crucial role in providing nutrients and regulating body temperature [2]. According to the severity of the injury, which is based on the look of the skin rather than the depth of the burn, burns are frequently classified as First-degree (superficial), second-degree (partial thickness), and third-degree (full thickness) burns are the three types of burn wounds that are distinguished by their depth. Burn wounds have a complicated, multi-stage healing process. It starts with inflammation brought on by damaged blood vessels and blood component leaking. Within hours of the damage, re-epithelialization begins, and granulation tissue is formed, mostly by fibroblasts and macrophages, which aid in the restoration of the extracellular matrix. Endothelial cell migration and division are accompanied by neovascularization, which is essential for the extracellular matrix in the wound bed. Cells, the extracellular matrix, and cytokines interact to promote wound contraction [3]. First-degree burns are regarded as minor and often only damage the epidermis, the outermost layer of skin. They often heal quickly without medical intervention, despite the fact that they can be extremely painful. Redness and flushing of the skin are characteristics of these burns [4]. There are two forms of second-degree burns: deep partial-thickness burns and superficial partial-thickness burns. The epidermis and a portion of the dermis are affected by superficial partial-thickness burns. They are frequently distinguished by the existence of blisters that are filled with transparent liquid. Although these burns usually hurt and need to be dressed and cared for, they usually go away without leaving any scars. Conversely, deep partial-thickness burns penetrate the dermis as well as the epidermis. Because they disrupt pain receptors, they may be less painful even though they are deeper. Scarring is more likely to occur from these burns, and surgery may occasionally be necessary. Full-thickness burns, another name for third-degree burns, pierce the skin’s outermost layer. Because nerve endings are destroyed, these burns frequently don’t cause any pain. Additionally, they harm the underlying subcutaneous tissue and blood arteries. Usually, a skin transplant, antibiotics, and the surgical excision of dead tissue are all part of the comprehensive course of treatment. These burns can affect deeper structures as well as the skin and subcutaneous tissue [5].

Figure No. 1] Illustrates the structure of human skin.
Ointment
Ointments are semi-solid compositions that, under shear stress, typically exhibit viscoelastic characteristics. Usually containing active therapeutic substances, their main purpose is topical treatment on the skin or mucous membranes. Commonly known as ointment bases, nonmedicated ointments are used to offer moisturizing or lubricating properties. These base materials can also be used to make medicinal ointments. When referring to emollient preparations with distinct properties, prescription language frequently uses phrases like creams, pastes, and cerates [6]. Ointments, creams, salves, or pastes are examples of semisolid preparations that are frequently used to apply medications topically to both undamaged and damaged skin as well as mucous membranes. The main purpose of these compositions is to moisturize or protect the skin. Although this function was fulfilled by traditional ointments, contemporary ointments also make it easier for drugs to enter the bloodstream [7]. Ointments and other semisolid dosage forms are frequently administered topically to the skin, eyes, nasal passages, vagina, or rectum for therapeutic, preventative, or aesthetic reasons. By enabling the medicine to permeate the surface, these formulations produce localized effects on the skin or mucous membranes at the application site. In order to treat skin disorders, ointments are made to provide drugs straight to the skin, which serves as the target organ. Usually, ointments are emulsions created by mixing water and oil, creating either water-in-oil (W/O) or oil-in-water (O/W) varieties. Small water droplets are scattered throughout a continuous oily phase in W/O emulsions, whereas tiny oil droplets are scattered in a continuous water phase in O/W emulsions.In general, ointments with both water and oil are simpler to remove with water, less greasy, and better suited for cosmetic applications[8].
Classification of ointment
Advantages of ointment
Disadvantages of ointment

Figure No. 2] Herbal Ointment
Plant Profile
1] Drug (Maytenus emarginata)
Maytenus emarginata (Willd) D. Hou., a member of the Celastraceae family, is an evergreen tree characterized by resinous stems and leaves. It commonly appears as small trees, shrubs, or lianas and is known for its ability to endure various desert conditions. Locally, it is called "vickado," while in Hindi it is known as "Kankero" and in English as the "thorny staff tree." This plant is also identified by its synonyms: Celastrus emarginatus Willd., Gymnosporia emarginata (Willd) Thw., and Gymnosporia montana (Roth) Benth. Traditionally, species of Maytenus have been widely utilized to manage ailments such as gastrointestinal disorders, fever, asthma, and rheumatism [9].

Figure No. 3] Maytenus Emarginata
Root: Used to treat digestive issues, particularly dysentery
Stem: The plant’s tender shoots aid in the treatment of oral ulcer. Using mustard oil, the bark is applied after being mashed into a paste to kill lice in the hair.
Leaf: Children are given crushed Maytenus emarginata leaves in milk as a vermifuge. A mouthwash made from a decoction of leafy twigs is used to treat toothaches. Using leaf ash to treat wounds and sores has a cooling effect. An ointment for wounds is made by burning the leaves and combining them with ghee. To treat jaundice, the delicate leaves are consumed uncooked [10].
Botanical classification and botanical description [11]:
Botanical classification
Kingdom: Plantae
Phylum: Magnoliophyta
Class: Magnoliopsida
Order: Celastrales
Family: Celestraceae
Genus: Maytenus
Botanical name: Maytenus emarginata (Willd.) Ding Hou
Synonyms:
Celastrus emarginatus Willd.
Gymnosporia emarginata (Willd.) Thw.
Gymnosporia Montana (Roth.) Benth.
Botanical description:
The Celastraceae family, which consists of roughly 50 genera and 850 species, often grows as trees or shrubs. The following is a list of all the Maytenus emarginata botanical descriptive characters:
Plant type: - Evergreen, Dioecious tree, very hard plant.
Growing requirements: - Light- full Sun with middy shade, Soil- sandy soil and lime soil, best growing season- monsoon, Drought tolerance- various types of stresses of desert.
Table No. 1]: Botanical Description of Maytenus emarginata (Willd)
|
Plant type |
Evergreen, Dioecious tree, very hardy plant. Habit: Scandent shrubs or small tree Name code: 202785 |
|
Growing requirements |
Light requirement: Full sun with midday shade Soil tolerances: Sandy soil, limestone Best season: Monsoon Drought tolerance: ? Various types of stresses of the desert |
|
Pale brown, smooth, cracked |
|
Thick, coriaceous and usually longer than 40mm, apex rounded, alternate on young branchlets, fasciculate on older ones |
|
Bisexual or sometimes functionally unisexual, actinomorphic, white or cream colored 5?7mm in diameter Male flower: ? Stamens slightly shorter than petals, stigmas absent, disc green, 5?lobed Female flower: Staminodes shorter than stamens of male flower, ovary 3?locular, green, style as long as ovary. |
|
Capsule, berry, 6?12mm long, green becoming red |
|
Tap root, Cream yellow in color |
|
Pest and disease |
Trouble free |
Botanical Description of Maytenus emarginata (Willd)
Phytochemical Constituents Present in Maytenus emarginat Plant
Table No. 2]: Phytochemical Constituents Present in Maytenus emarginata Plant
|
Sr. No. |
Phytochemical Constituents |
|
1 |
Flavonids |
|
2 |
Tannins |
|
3 |
Phlobatannins |
|
4 |
Saponins |
|
5 |
Steroid |
|
6 |
Cardiac glycosides |
|
7 |
Triterpenes |
|
8 |
Alkaloids |
|
|
|
|
|
|
|
|
|
2]. Curcuma Longa:
General Description of Curcuma Longa:
Turmeric is a plant with a subterranean stem, or rhizome, that resembles ginger. It is a herbaceous, perennial plant that grows to a height of 60–90 cm and has tufted leaves on short stems. Its yellow flowers, measuring between 10 and 15 cm in length, bloom from late spring to mid-growing season and are arranged in dense spikes. This shrub does not produce any fruit. The turmeric rhizome has a rough, segmented outer surface. When ground, its dull orange interior transforms into a vibrant yellow color. It measures about 2.5 cm in diameter and ranges from 2.5 to 7.0 cm in length, with small branching tubers. In traditional Indian Ayurvedic medicine, turmeric was highly valued. It was prescribed in Ayurveda to treat various ailments, including skin disorders and constipation. Additionally, it was used as a digestive aid and a remedy for liver-related issues such as fever, inflammation, wounds, infections, dysentery, arthritis, injuries, jaundice, and more. In Unani medicine, turmeric is considered the top herb for treating blood-related disorders due to its ability to purify, stimulate, and strengthen the blood. Among Indians, including housewives and Himalayan hermits, turmeric is widely known as the “Kitchen Queen” and is the most essential spice in cooking. A short-term Pancha Karma treatment is said to have similar benefits to the long-term use of triphala, tulsi, and turmeric. Additionally, turmeric possesses a broad spectrum of antifungal properties [12].

Figure No. 4] Curcuma Longa
Curcuma Longa Plant Profile [12]:
Family: Zingiberaceae
Synonym: Ameshta Indian saffron Haldi Halud Haridra Ameshta Curcuma Kunyit Kunyitbasah
Chemical Constituents: curcumin, demethoxycurcumin, and bisdemethoxycurcumin
Medicinal Uses: anti-inflammatory, antioxidant, and antimicrobial properties, supporting health conditions like arthritis, diabetes, and digestive issues.
Taxonomical Classification [13]:
Class- Liliopsida
Subclass- Commelinids
Order- Zingiberales
Family- Zingiberaceae
Genus- Curcuma
Species- Curcuma longa
Microscopic Characters [12]
The outermost layer of turmeric rhizomes is made up of four to six layers of brick-shaped parenchymatous cork, which is followed by the cork cambium. Round, thin-walled parenchymatous cells with sporadic vascular bundles make up the cortex. The cortex contains oleo-resin cells and brownish collateral vascular bundles. Vascular bundles are scattered throughout the pith region, creating a discontinuous ring underneath the distinct endodermis. There are a lot of starch granules, which range in size from 5 to 15 microns [12].
Morphology of the plant [14].
Root: Root initials develop from the diffuse meristem, a small cell zone located beneath the second or third node that separates the inner and outer ground tissues. This meristem extends from the primary elongating meristem. The root meristem itself arises from the diffuse meristem. At the root apex of turmeric, three sets of initials emerge from the diffuse meristem: one for the root cap, another for the plerome, and a shared zone for the dermatogens and plerome.

Figure No. 5] Roots of Curcuma Longa
Flowers: The flower is smaller than the bracts, featuring a reddish and pastel yellow border. The calyx is obtuse, three-toothed, and measures 10-15 mm in length. The flower itself is long, tubular, and semi-elliptic, with three lobes and a pale-yellow lip. Delicate and short-lived, the flowers have a thin texture and reach approximately 5 cm in length. The short, toothed, tubular calyx is split nearly halfway down one side. The corolla, tubular at the base and cup-shaped in the upper part, has three uneven lobes inserted on the cup lip. It features a hooded dorsal lobe that is transparent, thin, and pale.

Figure No. 6] Flower of Curcuma Longa
Fruit and seed: The ripe fruit resembles a small garlic bulb and has a white color. Mature seeds appear brownish-black, while immature seeds range from white to light brown. In some cases, seeds from the same fruit may exhibit embryos at different stages of development. Structurally, the embryos resemble those of cardamom and are distinctly monocotyledonous. Even in developed seeds, the nucellus remains present.
Leaves: The leaves, which grow in tufts, have long stalks or sheaths that form a pseudostem or aerial shoot. They can be alternate, obliquely erect, or subsessile. The upright leafy shoots rarely exceed one meter in height, and each sprout typically bears six to ten leaves. The slender petiole abruptly expands into the sheath. The sheaths enclosing the ligules have ciliate margins, while the ligule lobes themselves are small. The leaf blade is thin, lanceolate, and acuminate, featuring pellucid patches. It is dark green on the upper surface and pale green on the underside. While it usually reaches up to 30 cm in length and 7-8 cm in width, it can occasionally grow as long as 50 cm.

Figure No. 7] Leaves of Curcuma Longa
Nodes and Internodes: Mature mother rhizomes typically contain 7 to 12 nodes, with internodes measuring between 0.3 and 0.6 cm in length. However, the first few internodes at the proximal end are expanded, enabling the mother rhizome to reach the surface of the soil. The internodes of the primary and secondary fingers are approximately 2 cm longer than those of the mother rhizomes. Except for the first one or two nodes, every node on the mother rhizome and its fingers contains axillary buds. Secondary and tertiary branches bear only scale leaves. Branches exhibiting negative geotropic growth feature sheath or pointed scale leaves.
Aerial Shoot: The buds of the foliage leaves grow from the main finger and from the axils of the nodes of the underground bulb; the foliage leaf’s petiole is long and has a thick leaf sheath; the aerial shoot forms when the long leaf sheaths overlap.
Shoot Apex: A tunica-corpus structure is seen in the shoot’s apical meristem. Cells in the corpus, which is situated directly beneath the tunica, divide in a variety of directions, but cells in the tunica, which is composed of two layers, divide anticlinally. The ground meristem develops from a file of cells generated by the central rib meristem beneath the corpus layer. The procambium, cortical region, and leaf primordium are formed by the flank meristem, which surrounds this central area.
Rhizome: Turmeric’s underground stem, known as the rhizome, usually has a single major axis. Typically, planting material consists of a mother rhizome, sometimes referred to as the “seed rhizome,” or a whole finger. The aerial leafy shoot develops from a single main axis produced by this seed rhizome. The first rhizome unit, which eventually develops into the mother rhizome, is formed by the expansion of the base of the main axis.

Figure No. 8] Rhizomes of Curcuma Longa
LITERATURE REVIEW
AIM AND OBJECTIVES
AIM: Formulation and evaluation of herbal ointment of Maytenus emarginata for burning skin.
OBJECTIVES:
METHODOLOGY AND MATERIALS
Ingredients
Table No. 3] Ingredients
|
Sr. No. |
Ingredients |
|
1 |
Bees wax |
|
2 |
Wool fat |
|
3 |
Liquid Paraffin |
|
4 |
Coconut oil |
|
5 |
Rose water |
|
6 |
Maytenus emarginata extract |
|
7 |
Turmeric extract |
Collection of plant
The leaves of Maytenus emarginata were collected during August 2024 from areas of Saygata forest, Bramhapuri, Chandrapur district, Maharashtra. The leaves were washed throughly under running tap water 2-3 times to remove dirt and it burnt into oven and grind to fine powder with the help of mechanical grinder and store in airtight container.
Preparation of Herbal Extract
Leaves of the plant were collected and washed thoroughly with distilled water and burn the leave and grind in fine powder. 100gm powder was imbibed with 350ml of 90% ethanol for 3hrs. and transferred to conical flask with addition of 150ml of 90% ethanol for maceration for 7 days with occasional stirring. Finally, ethanolic extract was collected and concentrated to get blackish green residue. The extract was stored in the airtight container in cool and dark place.
Collect and wash the leaves with clean water
Burn the leaves and grind the leaves into fine powder
Take 100 gm of powder and add 350ml of 90% ethanol for 3 hrs
Transfer the mixture into conical flask and add 150 ml of 90 % thanol and let it sit for 7 days with occasionally stirring
Collect the liquid extract and remove the ethanol by heating or evaporation, leaving a dark green residue
Store the extract in a cool, dark place to presence its quality

Figure No. 9] Maceration Process
Phytochemical evaluation for Maytenus emarginata [15]
Test for tannins:
About 2 ml of filtered extract was taken in a test tube and 2 ml of ferric chloride was added. The presence of blue-black coloured precipitate indicated the presence of tannins.
Test for saponins:
To 0.5 ml of extract, 5ml of distilled water was added in a test tube. The solution was shaken vigorously and observed for stable persistent froth indicating presence of saponins.
Test for cardiac glycosides:
To 2 ml of extract 1 ml of glacial acetic acid containing one drop of ferric chloride solution was added. This was underlayed with 1ml of sulphuric acid. A brown ring at the interface indicated the presence of a deoxysugar characteristic of cardenolides. A violet ring may appear below the brown ring, while in the acetic acid layer a grennish ring may from just above the brown ring and gradually spread throughout this layer.
Test for Flavonoids:
Dilute ammonia about 5ml was added to the extract. Concentrated sulphuric acid 1ml was added to this reaction mixture. A yellow colouration that disappears on standing indicates the presence of flavonoids.
Test for steroid:
To 1ml extract 1ml of chloroform was added; then 1ml of concentrated sulphuric acid was added carefully to form coloured layer. Upper layer turns red. Sulphuric acid layer forms yellow with green fluoresence, indicates thr presence of steroid.
Test for triterpenes:
To 1ml of extract 1nl of chloroform was dded, then 1ml of concentrated sulphuric acid was added. Apperane of yellow colour in the lower layer of the solution in standing indicates the presence of triterpens.
Test for alkaloid:
To 1ml of extract, few drops of Mayer’s Reagent (1.36g of mercuric chloride and 5g of potassium iodide in 100 ml of distilled water) were added. The presence of creamy yellow colourd precipitate indicated the presence of alkaloids.
Mayer’s test: Take 1ml of extract in the test tube and add 2-3 drops of mayre’s reagent, a dull white precipitate indicate the presence of alkaloids.
Dragendoff’s test: Take 1ml of extract in the test tube and add 2-3 drops of Dragendroff’s reagent, orange precipitate give positive results.
Wagner’s test: Take 1ml of extract in the test tube and add 2-3 drops of Wagner’s reagent, presence of brown precipitate indicates the presence of alkaloids.
Phytochemical evaluation for curcuma longa [16]
Test for Alkaloid
Dragendroff's reagent was used to test this, and Wagner's reagent was used to confirm it. In a test tube, 3ml of crude ethanolic extract was placed, and 1ml strong HCl acid was slowly added. The mixture was warmed for 20 minutes, then cooled before being filtered through Whatman No 1 filter paper (125mm diameter.) After that, the filtrate was put through the Dragendroff and Wagner tests.
Test for Tannins
3mL plant extract was combined with an equivalent amount of newly produced FeCl3. The presence of tannin was revealed by a green coloration.
Test for Coumarin
1.5 mL NaOH (0.25 M, 10%) was combined with 2 mL Turmeric extract. The presence of Coumarin was demonstrated by the production of a yellow colour.
Test For Saponin
In 5ml distilled water 40mg extract was dissolved with vigorous shaking till a stable persist froth was obtained. In froth 2-3 olive oil drops were added with vigorous shaking.
Test for Diterpenes
The copper acetate test was used to accomplish this test. A dropper was used to add 10 drops of copper acetate solution to 1ml of turmeric extract and an equal amount of water. A rich green coloration was found, indicating the presence of diterpenes.
Test For Pholbatannis
1 mL of the plant extract was combined with 1 percent HCl acid (dilute) and gently heated. The presence of phlobatannins was shown by the formation of a reddish-brown precipitate.
Test for Glycosides
The Legal's test was used to look for cardiac glycosides, which involved mixing 1 mL pyridine with 3 mL ethanolic Turmeric extract. A dropper was used to add 5 drops of freshly made 2 percent sodium nitroprusside solution and 5 drops of 20 percent NaOH solution. A pinkish-red coloration was detected, which faded into brownish-yellow after standing for a while, indicating the presence of cardiac glycosides.
Test for Phenol
In a test tube, 1ml of the extract was combined with 4 drops of freshly made alcoholic FeCl3 solution. The plant extract has a bluish-black coloration, indicating that phenol is present.
Preparation of herbal ointment (Fusion method):
Ointment containing beeswax, wool alcohol and coconut oil are prepared by melting ingredients in a porcelain dish over a water bath. In this process higher melting point substance should be melted first and add then other ingredients of the bases in order of their melting point. After melting all bases ingredients the herbal extract add drop wise in the melted base with continuous stirring. Remove from waterbath and allow to cool down at room temperature with continuous stir.
Take beeswax, wool alcohol and coconut oil in beaker
Put into waterbath for melting
Take herbal extract, liquid paraffin in another beakere
After melting the bases, herbal extract are add dropwise in bases and stir continuously
After ointment are make add rose water as preservative and pour into suitable container
Table No. 4] Formulation of bases
|
Sr.No. |
Name of bases |
Quantity to be taken (g or ml) |
|
1 |
Bees wax |
4.5 |
|
2 |
Wool fat |
1.5 |
|
3 |
Liquid paraffin |
2 |
|
4 |
Coconut oil |
3.5 |
Different formulations of ointment
Table No 5] Different formulations of ointment
|
Sr. No. |
Ingredient |
Quantities are taken in ml or g |
||
|
|
|
F1 |
F2 |
F3 |
|
1 |
Bees wax |
4.5 |
5 |
4 |
|
2 |
Wool fat |
1.5 |
2 |
1 |
|
3 |
Liquid Paraffin |
1.5 |
1 |
2.5 |
|
4 |
Coconut oil |
2.5 |
1 |
3.5 |
|
5 |
Rose water |
q.s |
q.s |
q.s. |
|
6 |
Maytenus emarginata extract |
0.5 |
1 |
1.5 |
|
7 |
Turmeric extract |
0.3 |
0.6 |
0.9 |
1. Physical determination:
The Prepared ointment formulations were inspected visually by
a) Colour
b) Homogeneity
c) Consistency
2 Viscosity
The viscosity of the prepared gel formulations was determined using BrookField DV-III ULTRA programmable rheometer model RV, helipath spindle set (Brookfield Engineering laboratories, USA) using 4-bar spindle. The viscosity was measured in centipoises (cps) at 6 rpm for 1 minute and temperature 25ºC using 20-gram sample. This experiment was performed for medicated formulations.
3 Spreadability:
The spreadability is expressed in terms of time in seconds taken by two slides to slip off from ointment, placed in between two slides under the direction of certain load. Lesser the time taken for separation of two slides, the better the spreadability of ointment. The spreadability was calculated by using the following formula.
S=M.L/T
Where, M = weight tied to upper slide
L = length of glass slides
T = time taken to separate the slides

Figure No. 10] Spreadability
4 Determination of pH:
2.5gm Ointment sample was taken in 100 ml dry beaker, 50 ml water was added to it. Beaker was heated on water bath maintained at about 60ºC to 70ºC for 10 minutes, cooled to room temperature. The pH of water extract was measured by using pH meter. The pH measurements were done by using a digital type pH meter by dipping the glass electrode into the ointment formulation.

Figure No. 11] Determination of pH
5. Skin irritation studies:
Ointment formulation was evaluated for the non-irritancy test. Apply the ointment on skin and Observation of the sites was done for 30mins.
6. Washability
Formulation was applied on the skin and then easy extend of washing with water was checked.
In-vitro diffusion study for anti-bacterial activity:
In Vitro diffusion study: Antibacterial activity: The antibacterial screening of herbal gels was done by disc diffusion method. The gels were tested against bacterial agents namely E. coli. A loopful of the pure bacterial culture was suspended in nutrient broth and incubated for 24 hours. Nutrient agar media was sterilized and poured into petri plates. After solidification, 0.1ml of the inoculum was spread over the agar evenly using a rod. 6mm diameter cavity was prepared and formulated gel is placed in the cavity. A standard antibiotic was used as the control. The inoculated plates are incubated for 24 hours. Later, the zone of inhibition around the disc was measured and recorded.

Figure No. 12]: Zone of inhibition F2

Figure No. 13] Zone of inhibition F3
RESULTS AND DISCUSSION
Phytochemical Constituents Present In Maytenus emarginata Plant
Table No. 6]: Phytochemical Constituents Present In Maytenus emarginata Plant
|
Sr. No. |
Phytochemical Constituents |
Observation |
Result |
|
1 |
Flavonids |
Yellow colour disappears |
+ |
|
2 |
Tannins |
Blue-black coloured observed |
+ |
|
3 |
Saponins |
Stable persistent froth not observed |
- |
|
4 |
Steroid |
Green fluorescence observed |
+ |
|
5 |
Cardiac glycosides |
Grennish ring observed |
+ |
|
6 |
Triterpenes |
Yellow colour observed |
+ |
|
7 |
Alkaloids |
Creamy yellow coloured observed |
+ |
|
|
|
Dull white ppt observed |
+ |
|
|
|
Orange ppt not observed |
- |
|
|
|
Brown ppt observed |
+ |
Phytochemical Constituents Present In curcuma longa Plant
Table No. 7] Phytochemical Constituents Present In curcuma longa Plant
|
Sr. No. |
Phytochemical Constituents |
Observation |
Result |
|
1 |
Tannins |
Green colour observed |
+ |
|
2 |
Coumarin |
Yellow colour observed |
+ |
|
3 |
Saponins |
Stable persist froth not observed |
- |
|
4 |
Diterpenes |
Rich green colour observed |
+ |
|
5 |
Glycosides |
Brownish yellow colour observed |
+ |
|
6 |
Phenol |
Bluish-black colour not observed |
- |
|
7 |
Alkaloids |
|
|
|
|
|
Creamy ppt observed |
+ |
|
|
|
Brownish ppt observed |
+ |
Physical evaluation
Table No. 8] Physical evaluation
|
Sr. No. |
Formulation |
colour |
Consistency |
Odor |
Homogeneity |
|
1 |
F1 |
Yellow |
Good |
Characteristc |
Good |
|
2 |
F2 |
Yellow |
Good |
Characteristc |
Good |
|
3 |
F3 |
Yellow |
Good |
Characteristc |
Good |
PH
Table No. 9] PH
|
Sr. No. |
Formulation |
PH |
|
1 |
F1 |
6.33 |
|
2 |
F2 |
6.45 |
|
3 |
F3 |
6.53 |
The herbal ointment containing Maytenus emarginata or curcuma longa extract has pH range of 6.33 to 6.53, which is slightly acidic to neutral.
Viscosity
Table No. 10] Viscosity
|
Sr. No. |
Formulation |
Viscosity |
|
1 |
F1 |
3053 cP |
|
2 |
F2 |
3456 cP |
|
3 |
F3 |
3865 cP |
The viscosity is illustrated according to the change in type of fatty alcohol and concentration and the molecular weight of the ointment bases. found that increasing the concentration of the emulsifying agent in the ointment’s formulation led to increased viscosity of the formulation.
Spreadability
Table No. 11] Spreadability
|
Sr. No. |
Formulation |
Spreadability |
|
1 |
F1 |
100gcm/sec |
|
2 |
F2 |
87.50 gcm/sec |
|
3 |
F3 |
79.85 gcm/sec |
Pharmaceutical semisolid preparations of ointment. Their common property is the ability to cling to the application surface for a reasonable period before they are washed off or worn off. They usually serve as vehicles for topically applied drugs, as emollients, or as protective.
Skin Irritation Test: Minor or No irritation observe
The herbal ointment with wax bases that contains extracts of Maytenus emarginata or Curcuma longa is probably going to be mild on the skin, reducing the possibility of discomfort. The anti-inflammatory and antioxidant qualities of Maytenus emarginata and Curcuma longa are well-known for their ability to calm and shield the skin. The wax base functions as a barrier to prevent irritation and promote the effectiveness of the herbal extracts. Sensitive skin or skin disorders that call for mild, non-irritating treatments might benefit from this formulation.
Washability: Cannot remove with water
Herbal ointment contain wax bases are typically anhydrous or water-free formulation. Due to ther hydrophobic property these ointment cant not removed with water.
Anti-bacterial activity: the anti-bacterial test of ointment from Maytenus emarginata leaves extaract show promising result the study has demonstrated that the extract exhibits significant antibacterial activity using E. coli bacterial culture the test of anti-bacterial activity are positive.
Table No. 12] Zone of inhibition
|
Microorganisms |
Zone of inhibition (cm) |
|
E.coli |
3.5 cm |
CONCLUSION
This study successfully formulated and evaluated a herbal ointment combining Maytenus emarginata and turmeric, demonstrating its potential as a topical treatment. The in vitro tests revealed promising results, indicating the ointment's effectiveness in a controlled environment. Furthermore, the formulation study showed that increasing the concentration of ointment base led to a significant increase in viscosity, while lower concentrations exhibited better spreadability. Specifically, formulation F1, with the lowest ointment base concentration, demonstrated optimal spreadability, suggesting its potential as a topical application. These findings provide a foundation for further research and development of this herbal ointment, with potential applications in wound healing, skin care, and other topical therapies. Future studies can focus on in-vivo testing, stability studies, and scaling up the formulation for commercial production.
REFERENCES


Tushar Wagh*, Pooja Ghutke, Formulation and Evaluation of Herbal Ointment of Maytenus Emarginata for Burning Skin, Int. J. of Pharm. Sci., 2025, Vol 3, Issue 7, 330-351. https://doi.org/10.5281/zenodo.15790623
 10.5281/zenodo.15790623
10.5281/zenodo.15790623